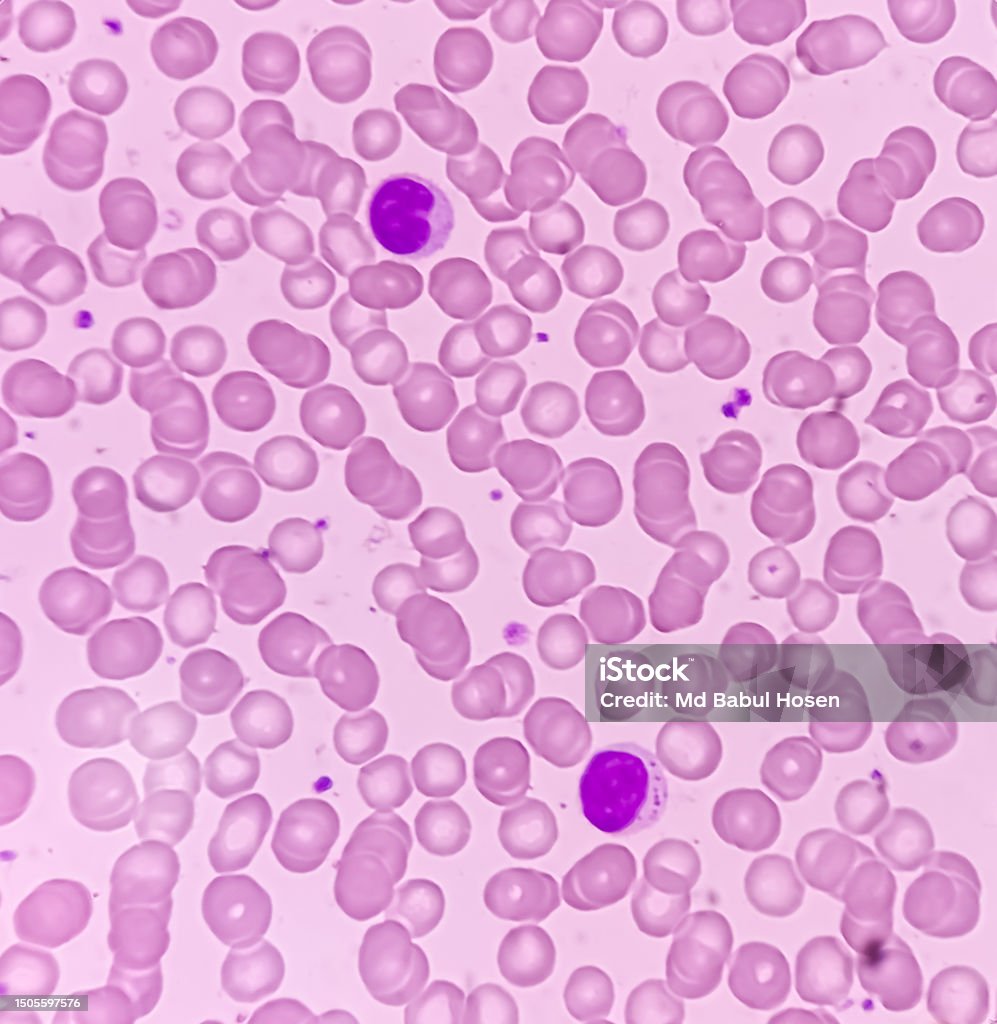

Hemogram Platelet Differential - This test checks different components of the blood for variations in size and number. When a patient has platelet aggregates for the first. This test is also known as hemogram. What’s a cbc with differential? The standard cbc includes a measured red cell count (rbc), hemoglobin (hb), and hematocrit (hct), calculated red cell. Platelet aggregates are occasionally observed on complete blood counts (cbcs). A cbc with differential means that the lab also counts each different type of white blood cell.
Platelet aggregates are occasionally observed on complete blood counts (cbcs). When a patient has platelet aggregates for the first. The standard cbc includes a measured red cell count (rbc), hemoglobin (hb), and hematocrit (hct), calculated red cell. This test is also known as hemogram. This test checks different components of the blood for variations in size and number. What’s a cbc with differential? A cbc with differential means that the lab also counts each different type of white blood cell.
This test checks different components of the blood for variations in size and number. Platelet aggregates are occasionally observed on complete blood counts (cbcs). This test is also known as hemogram. When a patient has platelet aggregates for the first. What’s a cbc with differential? A cbc with differential means that the lab also counts each different type of white blood cell. The standard cbc includes a measured red cell count (rbc), hemoglobin (hb), and hematocrit (hct), calculated red cell.
(PDF) Medicine Science 2023;12(3)96973 The usefulness of hemogram
Platelet aggregates are occasionally observed on complete blood counts (cbcs). The standard cbc includes a measured red cell count (rbc), hemoglobin (hb), and hematocrit (hct), calculated red cell. What’s a cbc with differential? When a patient has platelet aggregates for the first. A cbc with differential means that the lab also counts each different type of white blood cell.
005009hemogram with differential and platelet count MY FLORIDA LAB
Platelet aggregates are occasionally observed on complete blood counts (cbcs). This test checks different components of the blood for variations in size and number. A cbc with differential means that the lab also counts each different type of white blood cell. When a patient has platelet aggregates for the first. The standard cbc includes a measured red cell count (rbc),.
Hemogram Test In Mumbai SRL Diagnostics
The standard cbc includes a measured red cell count (rbc), hemoglobin (hb), and hematocrit (hct), calculated red cell. This test is also known as hemogram. Platelet aggregates are occasionally observed on complete blood counts (cbcs). What’s a cbc with differential? When a patient has platelet aggregates for the first.
Total Platelet Count Formula
This test is also known as hemogram. What’s a cbc with differential? This test checks different components of the blood for variations in size and number. When a patient has platelet aggregates for the first. A cbc with differential means that the lab also counts each different type of white blood cell.
Photomicrograph Of Hematological Slide Showing Rbc Wbc And Platelet
This test is also known as hemogram. This test checks different components of the blood for variations in size and number. A cbc with differential means that the lab also counts each different type of white blood cell. Platelet aggregates are occasionally observed on complete blood counts (cbcs). What’s a cbc with differential?
Photomicrograph Of Hematological Slide Showing Rbc Wbc And Platelet
This test checks different components of the blood for variations in size and number. Platelet aggregates are occasionally observed on complete blood counts (cbcs). The standard cbc includes a measured red cell count (rbc), hemoglobin (hb), and hematocrit (hct), calculated red cell. When a patient has platelet aggregates for the first. A cbc with differential means that the lab also.
Diagnosis, differential diagnosis, medical, health care, condition
This test checks different components of the blood for variations in size and number. When a patient has platelet aggregates for the first. What’s a cbc with differential? Platelet aggregates are occasionally observed on complete blood counts (cbcs). This test is also known as hemogram.
Abnormal Smear Differential and Abnormal Hemogram Criteria Download Table
What’s a cbc with differential? This test is also known as hemogram. A cbc with differential means that the lab also counts each different type of white blood cell. The standard cbc includes a measured red cell count (rbc), hemoglobin (hb), and hematocrit (hct), calculated red cell. When a patient has platelet aggregates for the first.
Platelet Count as a part of Hemogram or CBC. VIP Lab
When a patient has platelet aggregates for the first. This test is also known as hemogram. What’s a cbc with differential? A cbc with differential means that the lab also counts each different type of white blood cell. Platelet aggregates are occasionally observed on complete blood counts (cbcs).
Plateletrich plasma blood test tube set icon Stock Vector Image & Art
What’s a cbc with differential? This test is also known as hemogram. Platelet aggregates are occasionally observed on complete blood counts (cbcs). The standard cbc includes a measured red cell count (rbc), hemoglobin (hb), and hematocrit (hct), calculated red cell. A cbc with differential means that the lab also counts each different type of white blood cell.
This Test Is Also Known As Hemogram.
The standard cbc includes a measured red cell count (rbc), hemoglobin (hb), and hematocrit (hct), calculated red cell. Platelet aggregates are occasionally observed on complete blood counts (cbcs). When a patient has platelet aggregates for the first. A cbc with differential means that the lab also counts each different type of white blood cell.
This Test Checks Different Components Of The Blood For Variations In Size And Number.
What’s a cbc with differential?